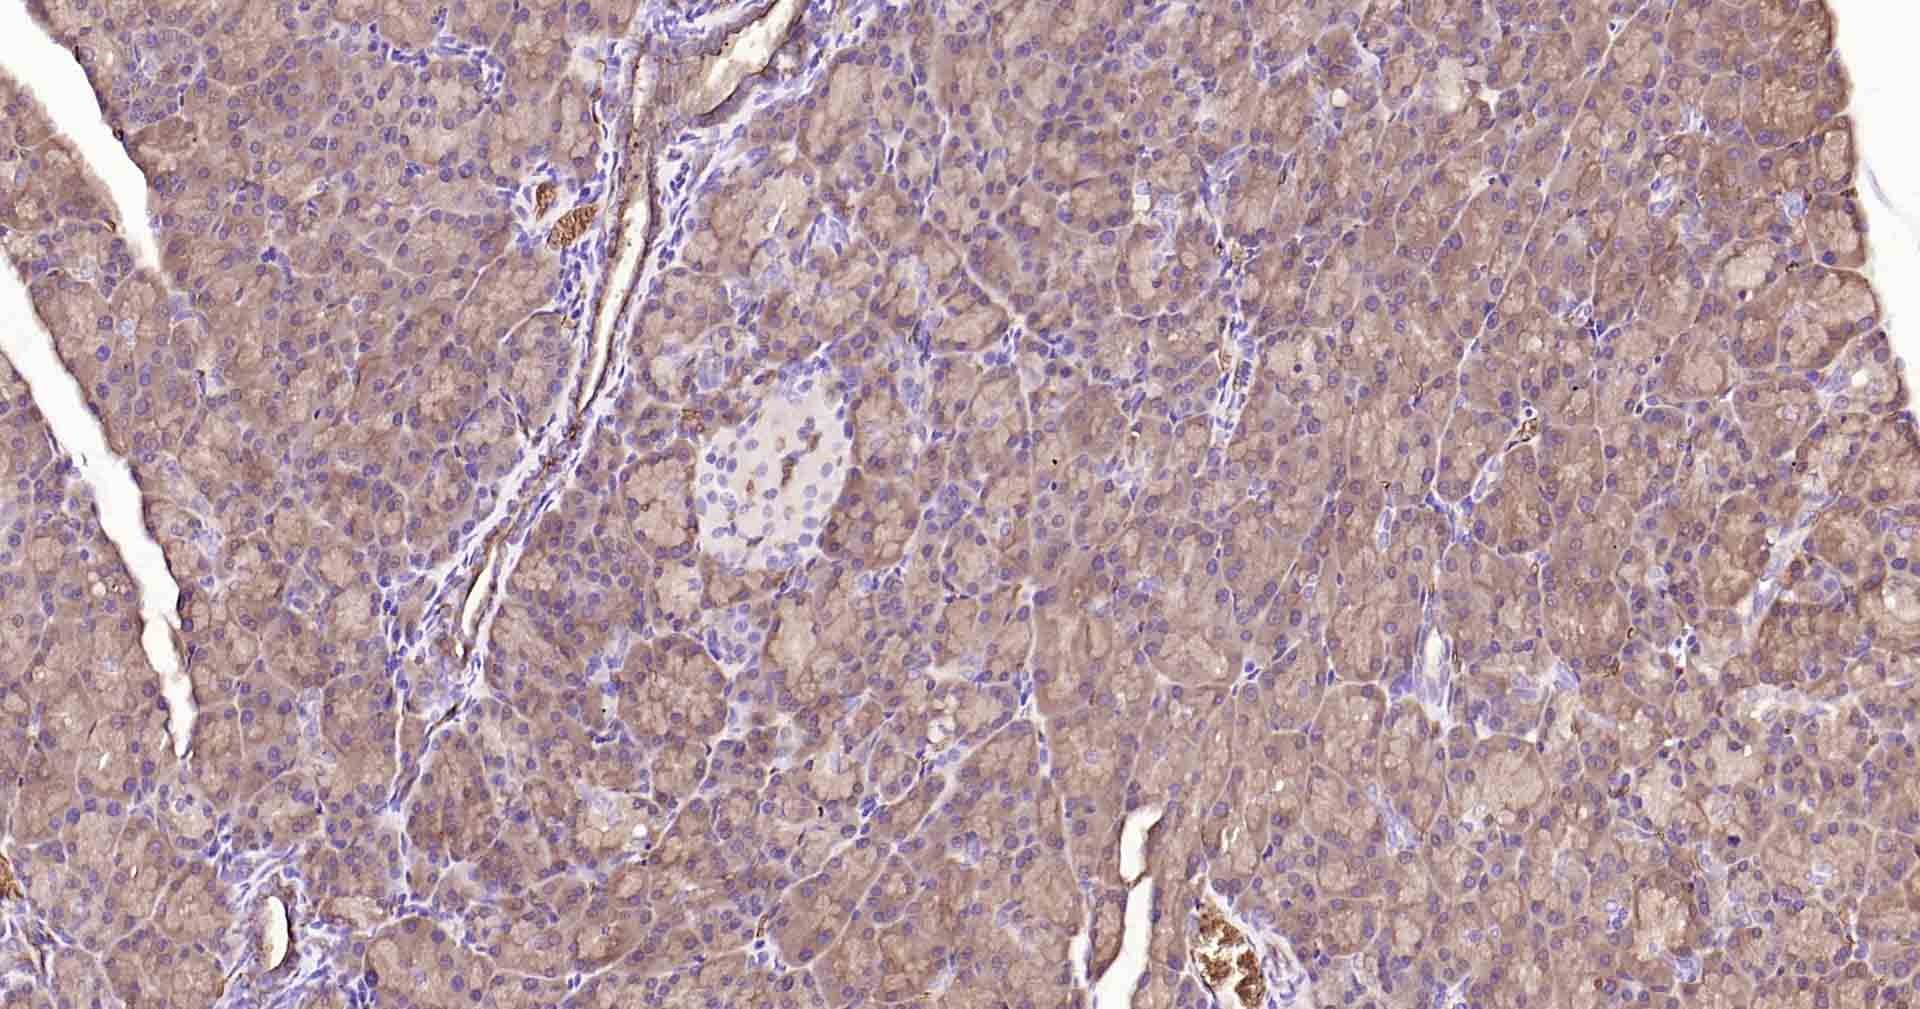
水通道蛋白1重组兔单抗

水通道蛋白1重组兔单抗
Rrmab?兔单抗

货号:bsm-52909R
产品详情
相关标记
相关产品
相关文献
常见问题
概述
产品编号
bsm-52909R
产品类型
重组兔单抗、mIHC精品抗体
英文名称
AQP1 Recombinant Rabbit mAb
中文名称
水通道蛋白1重组兔单抗
英文别名
AQP-CHIP; CHIP28; CO; AQP-1; CHIP29; AQP1_BOVIN; AQP1; Aquaporin-CHIP; Water channel protein CHIP29; AQP1_CANLF; AQP1_HUMAN; Channel-like integral membrane protein of 28 kDa; Urine water channel; AQP1_MOUSE; Delayed early response protein 2 (DER2); AQP1_RAT; AQP1_SHEEP;
抗体来源
Rabbit
免疫原
A synthesized peptide derived from human Aquaporin 1: 214-269
亚型
IgG
性状
Liquid
纯化方法
affinity purified by Protein A
克隆类型
Recombinant
克隆号
2H11
理论分子量
28 kDa
浓度
1mg/ml
储存液
0.01M TBS(pH7.4) with 1% BSA, 0.02% Proclin300 and 50% Glycerol.
研究领域
SWISS
Gene ID
保存条件
Shipped at 4℃. Store at -20 °C for one year. Avoid repeated freeze/thaw cycles.
注意事项
This product as supplied is intended for research use only, not for use in human, therapeutic or diagnostic applications.
数据库链接
产品介绍
通道蛋白(Channel Protein)
背景资料
Aquaporin 1 is a 28kD integral membrane protein which was originally identified in red blood cells and renal proximal tubules. AQP1 is also expressed by the choroid plexus and various other tissues. It forms a water-specific channel that provides the plasma membranes of red cells and kidney proximal tubules with high permeability to water, thereby permitting water to move in the direction of an osmotic gradient.

产品应用
| 应用 | 已检合格种属 | 预测种属 | 推荐稀释比例 |
|---|---|---|---|
| WB | Mouse, Rat | Human | 1:1000-5000 |
| IHC-P | Human, Mouse, Rat | 1:200-1000 | |
| IHC-F | Human, Mouse, Rat | 1:200-1000 | |
| IF | Human, Mouse, Rat | 1:200-1000 |
交叉反应
交叉反应: Human, Mouse, Rat
相关产品
暂无相关产品
靶标
基因名
AQP1
蛋白名
Aquaporin-1
亚基
Homotetramer. Interacts with EPHB2; involved in endolymphproduction in the inner ear (By similarity).
亚细胞定位
Membrane; Multi-pass membrane protein.
组织特异性
Expressed in a number of tissues including erythrocytes, renal tubules, retinal pigment epithelium, heart, lung, skeletal muscle, kidney and pancreas. Weakly expressed in brain, placenta and liver.
相似性
Belongs to the MIP/aquaporin (TC 1.A.8) family.
功能
Forms a water-specific channel that provides the plasmamembranes of red cells and kidney proximal tubules with highpermeability to water, thereby permitting water to move in thedirection of an osmotic gradient.
标记抗体
暂无标记数据
同靶标产品
暂无同靶标产品
相关文献
提示: 发表研究结果有使用 bsm-52909R 时请让我们知道,以便我们可以引用参考文章。作为回馈,资料提供者将获得我们送上的小礼品。
暂无相关文献
常见问题
暂无常见问题